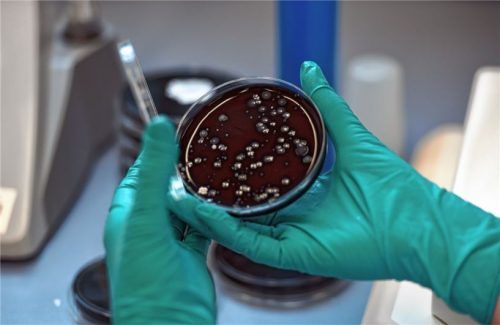
Diese Bakterienkultur besteht aus Legionellen. Durch sie ausgelöste Infektionskrankheiten registrierte das Gesundheitsamt heuer bereits 16-mal.Foto dpa

Allein im Juli sieben Fälle
Legionellen: 2018 schon 16 Infektionen
Diese Bakterienkultur besteht aus Legionellen. Durch sie ausgelöste Infektionskrankheiten registrierte das Gesundheitsamt heuer bereits 16-mal.Foto dpa
Bereits 16 Erkrankungsfälle, die durch Legionellen ausgelöst wurden, registrierte das Gesundheitsamt heuer in der Stadt und dem Landkreis Rosenheim. „Das ist seit Einführung der Meldepflicht im Jahr 2001 der bislang höchste Wert“, sagt Behördenleiter Dr. Wolfgang Hierl.
Rosenheim – Der Juli brachte eine traurige Rekordmarke. Sieben FälIe von Infektionserkrankungen, die durch die weltweit in Umwelt, in Oberflächenwässern und im Grundwasser vorkommenden Bakterien ausgelöst wurden, registrierte die Behörde „So viele Fälle wurden bisher noch nie in einem Monat gemeldet